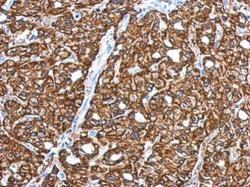

Antibody data
- Antibody Data
- Antigen structure
- References [0]
- Comments [0]
- Validations
- Western blot [2]
- Immunocytochemistry [1]
- Immunohistochemistry [1]
Submit
Validation data
Reference
Comment
Report error
- Product number
- GTX118270 - Provider product page

- Provider
- GeneTex
- Proper citation
- GeneTex Cat#GTX118270, RRID:AB_10722810
- Product name
- CRYZ antibody [N1C1]
- Antibody type
- Polyclonal
- Reactivity
- Human, Mouse
- Host
- Rabbit
No comments: Submit comment
Supportive validation
- Submitted by
- GeneTex (provider)
- Main image

- Experimental details
- Sample (30 ug of whole cell lysate) A: Jurkat B: Raji 10% SDS PAGE GTX118270 diluted at 1:1000
- Submitted by
- GeneTex (provider)
- Main image

- Experimental details
- Sample (50 ug of whole cell lysate) A: mouse brain 10% SDS PAGE GTX118270 diluted at 1:500
Supportive validation
- Submitted by
- GeneTex (provider)
- Main image

- Experimental details
- zeta Crystallin antibody [N1C1] detects zeta Crystallin protein at cytoplasm by immunofluorescent analysis.Sample: HepG2 cells were fixed in ice-cold MeOH for 5 min.Green: zeta Crystallin protein stained by zeta Crystallin antibody [N1C1] (GTX118270) diluted at 1:500.Blue: Hoechst 33342 staining.Scale bar = 10 £gm.
Supportive validation
- Submitted by
- GeneTex (provider)
- Main image
- Experimental details
- Immunohistochemical analysis of paraffin-embedded human hepatoma, using zeta Crystallin(GTX118270) antibody at 1:500 dilution.